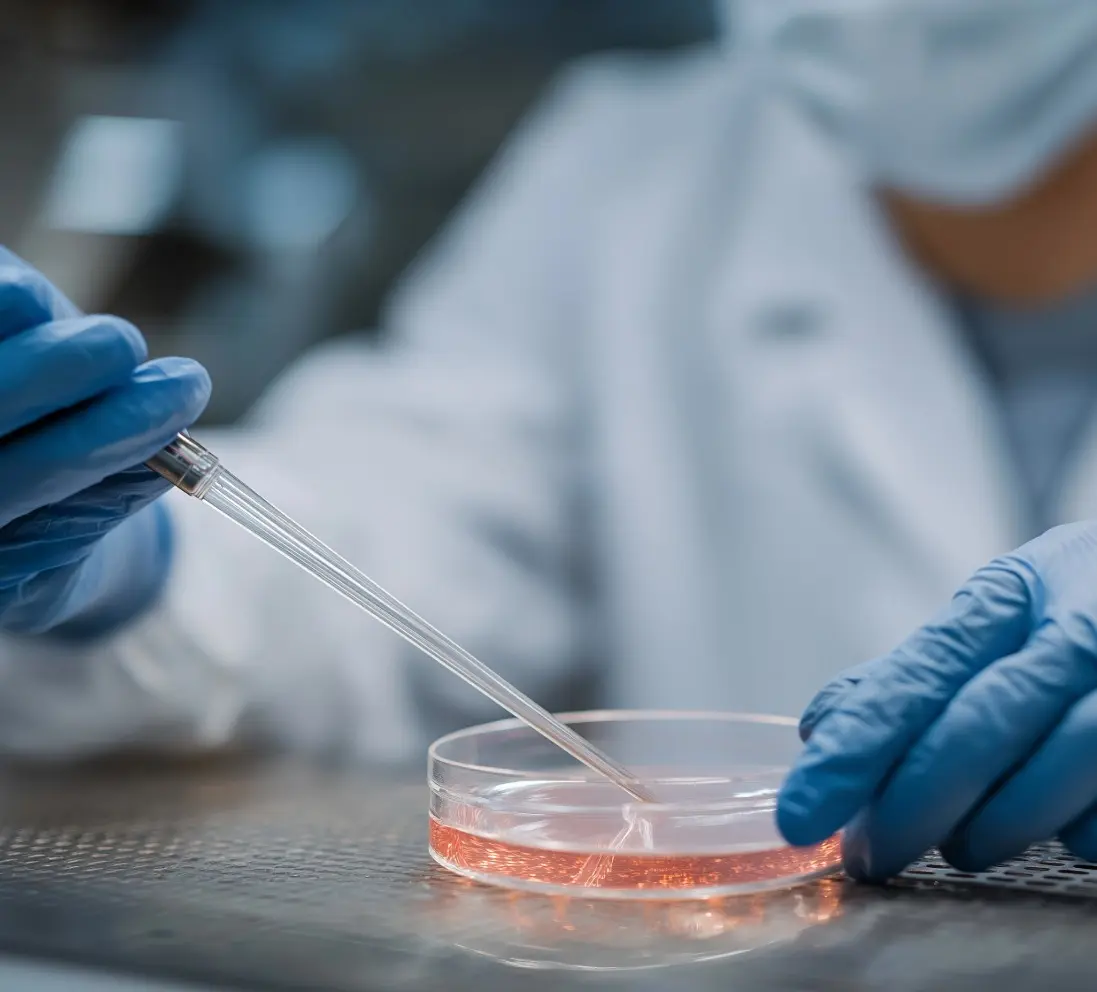
Analisi emulsione

Analisi microbiologiche aria
La qualità dell’aria che respiriamo è fondamentale per la salute pubblica, l’ambiente e il settore industriale.
Le analisi microbiologiche dell’aria sono procedure di laboratorio volte a
rilevare e quantificare la presenza di microrganismi (come batteri, funghi, muffe e virus) presenti nell’aria.
Queste analisi sono fondamentali per valutare la qualità dell’aria in ambienti come ospedali, laboratori, ambienti industriali, spazi pubblici e abitazioni,
al fine di garantire condizioni igieniche e prevenire rischi per la salute.
La nostra azienda offre
servizi di analisi altamente qualificati e affidabili
per garantire ambienti sicuri e conformi alle normative vigenti.
Servizi di Analisi Microbiologiche dell’Aria
- Conta microrganismi a 37°C: quantifica i microrganismi mesofili presenti nell’aria ed è fondamentale per valutare la presenza di batteri potenzialmente patogeni in ambienti sanitari e alimentari.
- Conta microrganismi a 20°C: rileva microrganismi psicrofili e mesofili utili per analizzare ambienti pubblici, uffici e contesti industriali.
- Conta Lieviti e Muffe: permette di monitorare la qualità ambientale e prevenire deterioramenti e rischi per la salute.
- Conta Enterobatteri: indicatori di contaminazione fecale e scarsa igiene, particolarmente rilevanti in ambienti sanitari e di produzione alimentare.
Perché Scegliere i Nostri Servizi?
Grazie a tecnologie all’avanguardia e a personale altamente qualificato, garantiamo risultati precisi e rapidi. La nostra missione è supportarti nel mantenere ambienti sani, sicuri e conformi alle normative vigenti.